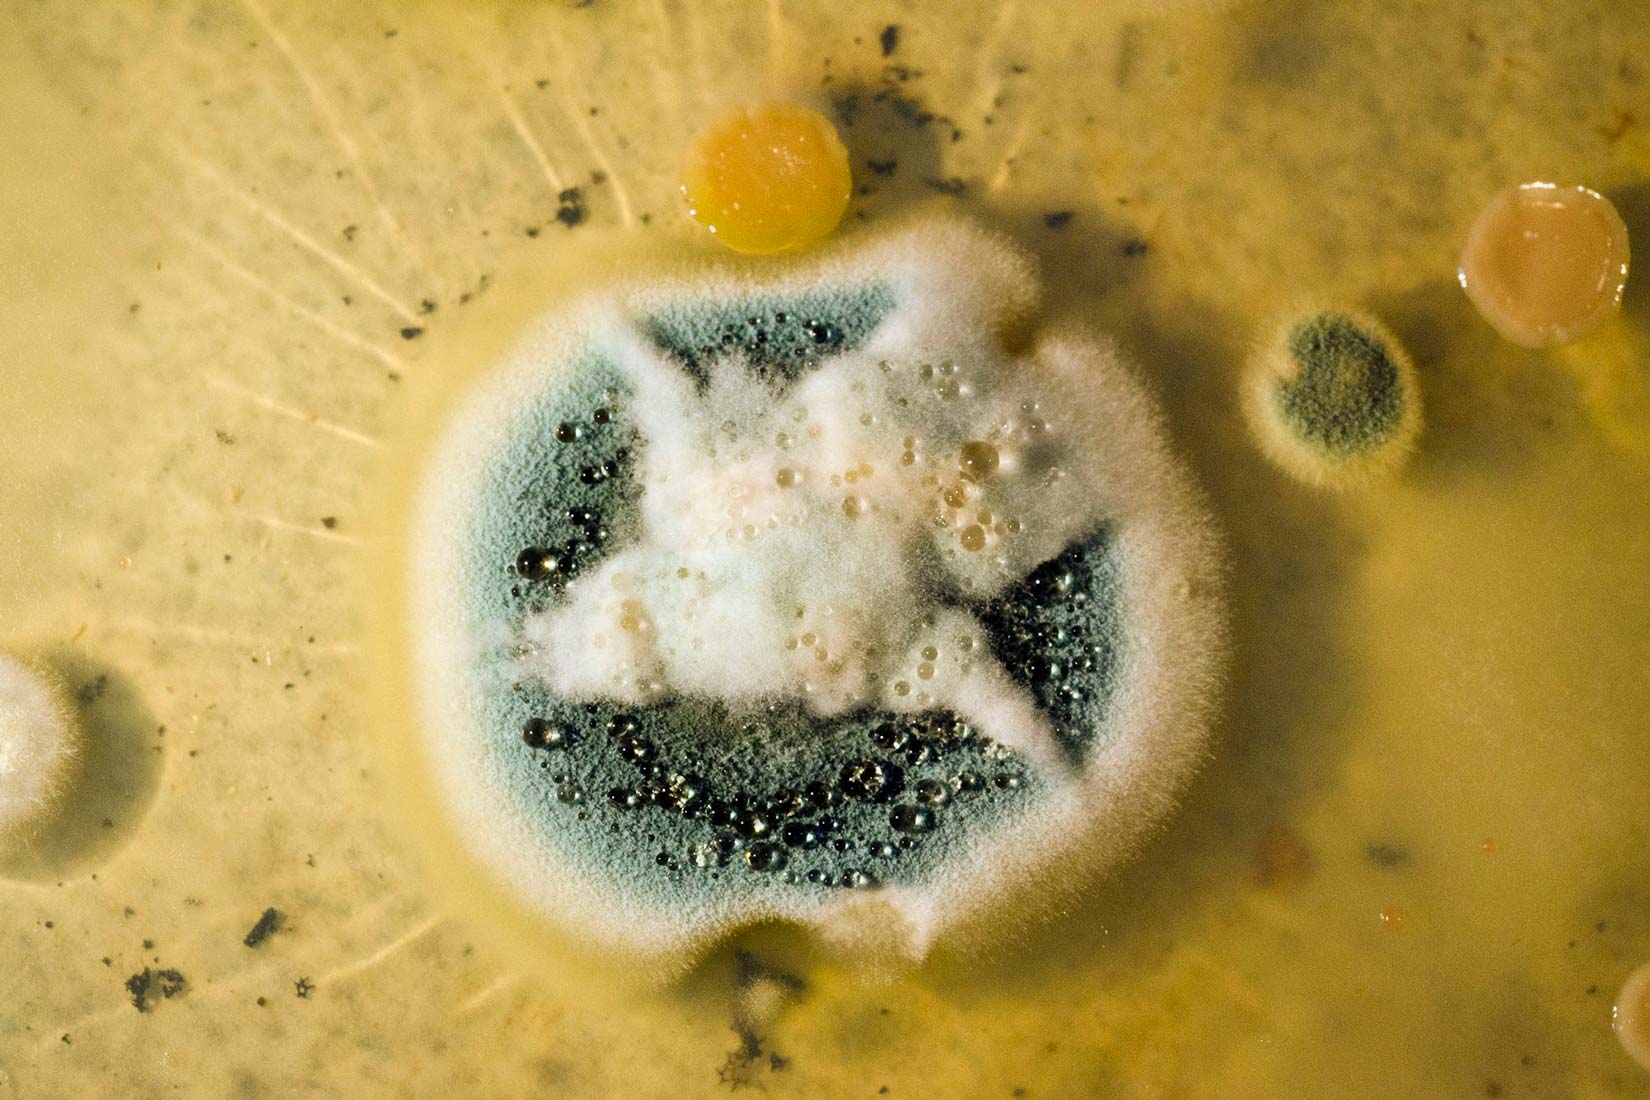

Fiziološko djelovanje tvari
- objasniti fiziološko djelovanje tvari,
- prosuditi važnost biokemije za svakodnevni život,
- prosuditi korisno i štetno djelovanje nekih kemikalija na ljudsko zdravlje (lijekovi, sredstva za osobnu higijenu, sredstva koja uzrokuju ovisnost, pesticidi, teški metali, ispušni plinovi i dr.).
Uvod
Najpoznatiji europski alkemičar bio je švicarski liječnik
Postavio je temelje suvremenog ljekarništva (farmacije).
Smatrao je da je svaka tvar može biti štetna
ako se uzme u neprimjerenoj količini.
Važno je odrediti pravu količinu tvari (doza tvari),
da bi bila korisna i ljekovita.
Poznata je njegova izreka:
«Sola dosis facit venenum» Paracelsus, 16. st.: „Samo doza čini otrov.“
Uvod
Najpoznatiji europski alkemičar bio je švicarski liječnik
«Sola dosis facit venenum» Paracelsus, 16. st.: „Samo doza čini otrov.“
Brojne biljke i životinje proizvode tvari koji im služe za obranu.
Neka južnoamerička plemena i danas
iz otrovnih biljaka pripremaju otrove.
Otrovima premazuju šiljke svojih kopalja i strijela.
Tako lakše usmrtie životinju koju love.
Različite tvari biljnog i životinjskog podrijetla
danas se istražuju i u brojnim
Pokazalo da u vrlo malim količinama mogu biti ljekovite.
Brojne biljke i životinje proizvode tvari koji im služe za obranu. Neka južnoamerička plemena i danas iz otrovnih biljaka pripremaju otrove kojima premazuju šiljke svojih kopalja i strijela kako bi u lovu lakše usmrtili životinju. Različite tvari biljnog i životinjskog podrijetla danas se istražuje i u brojnim
Svojstvo tvari da djeluje na živa bića naziva se
Znamo da vitamini i minerali korisno djeluju na naš organizam,
te ih svakodnevno koristimo.
Lijekovi povoljno djeluju na organizam.
Njih uzimamo samo kad nam to odredi liječnik
i samo u propisanoj količini.
Kemičari su otkrili i proizveli mnoge ljekovite tvari
bez kojih je suvremena medicina nezamisliva.
Otkrićem penicilina i drugih lijekova
mnoge se bolesti danas uspješno liječe.
Neke su potpuno iskorijenjene.
Sredstva za osobnu higijenu štite nas od raznih bolesti,
osobito bolesti prljavih ruku.
Ljekovite tvari rezultat su kemijskog znanja
i zajedničkih znanstvenih istraživanja kemičara, farmaceuta i liječnika.
Svojstvo tvari da djeluje na živa bića naziva se
Znamo da vitamini i minerali korisno djeluju na naš organizam te ih svakodnevno uzimamo. I lijekovi povoljno djeluju na organizam liječeći ga, ali njih uzimamo samo kad nam to odredi liječnik i samo u propisanoj količini.
Kemičari su otkrili i proizveli mnoge ljekovite tvari bez kojih je suvremena medicina nezamisliva. Otkrićem penicilina i drugih lijekova mnoge se bolesti danas uspješno liječe, a neke su potpuno iskorijenjene. Sredstva za osobnu higijenu štite nas od uzročnika raznih bolesti, osobito bolesti prljavih ruku.
Sve ljekovite tvari rezultat su kemijskog znanja i zajedničkih znanstvenih istraživanja kemičara, farmaceuta i liječnika.
Pencilin – prvi otkriveni antibiotik
Plijesni (gljivice) su u stalnoj borbi s bakterijama oko hrane.
Da bi se oslobodile bakterija, luče tvari koje su otrovne za bakterije.
Te tvari su poznate pod imenom antibiotici.
Alexander Fleming, škotski biolog, slučajno je 1928. godine
otkrio da zelena plijesan kistac ubija bakterije.
U početku se tom otkriću nije pridavala važnost
jer A. Fleming nije mogao proizvesti veće količine antibiotika.
Desetak godina kasnije, znanstvenici Howard Florey i Ernest Chain
uspjeli su usavršiti postupak za dobivanje penicilina.
Početkom 1941. godine uspjeli su nagovoriti američku vladu
i četiri američke tvrtke da počnu proizvoditi penicilin.
Za to otkriće sva trojica su 1945. godine dobila Nobelovu nagradu.
Nakon otkrića penicilina započela je široka primjena antibiotika.
Pokušajte objasniti važnost primjene penicilina
tijekom Drugog svjetskog rata.
Tada je bilo puno ranjenih ljudi koji su trebali penicilin.
Timskim radom istražite postoje li antibiotici
koji se proizvode iz nekih drugih organizama.
Svoje rezultate predstavite pomoću kratke i zanimljive prezentacije.
Pencilin – prvi otkriveni antibiotik
Plijesni su u stalnoj borbi s bakterijama oko hrane. Da bi se oslobodile bakterija, luče tvari koje su otrovne za bakterije. Te tvari su poznate pod imenom antibiotici.
Alexander Fleming, škotski biolog, slučajno je 1928. godine otkrio da zelena plijesan kistac ubija bakterije. Važnost ovog otkrića je ispočetka bila podcijenjena jer A. Fleming nije mogao proizvesti veće količine antibiotika. Desetak godina kasnije, znanstvenici Howard Florey i Ernest Chain uspjeli su usavršiti postupak za dobivanje penicilina. Početkom 1941. godine uspjeli su nagovoriti američku vladu i četiri američke tvrtke da počnu proizvoditi penicilin. Za to otkriće sva trojica su 1945. godine dobila Nobelovu nagradu. Nakon otkrića penicilina započela je široka primjena antibiotika.
Pokušajte objasniti važnost primjene penicilina tijekom Drugog svjetskog rata.
Timskim radom istražite postoje li antibiotici koji se proizvode iz nekih drugih organizama, a svoje rezultate predstavite pomoću kratke i zanimljive prezentacije.
Kemičari su svojim otkrićima pomogli razvoju suvremene poljoprivrede.
U suvremenoj poljoprivrednoj proizvodnji planski se koriste
različita gnojiva i
koji pospješuju ukupnu proizvodnju mnogih biljnih kultura.
Te se tvari smiju koristiti samo prema točnim uputama
kako ne bi došlo do onečišćenja vode, tla i hrane.
Kemičari su svojim otkrićima pomogli razvoju suvremene poljoprivrede.
U suvremenoj poljoprivrednoj proizvodnji planski se koriste različita gnojiva i
Istražite zašto je zabranjena proizvodnja pesticida zvanog DDT.
DDT je sredinom 20. stoljeća bio najkorišteniji insekticid.
S vremenom se pokazalo da se lako nakuplja
u potkožnom masnom tkivu i jetrima sisavaca.
Složenim hranidbenim lancima dospio je i do organizama na Arktiku.
Sporo se razgrađuje i postupno oštećuje organizam.
Dokazani je kancerogen (uzrokuje rak )
te je od 2001. godine njegova primjena strogo zabranjena.
Istražite zašto je zabranjena proizvodnja pesticida zvanog DDT.
DDT je sredinom 20. stoljeća bio najkorišteniji insekticid. S vremenom se pokazalo da se lako nakuplja u potkožnom masnom tkivu i jetrima sisavaca. Složenim hranidbenim lancima dospio je i do organizama na Arktiku. Sporo se razgrađuje i postupno oštećuje organizam. Dokazani je kancerogen te je od 2001. godine njegova primjena strogo zabranjena.
Nažalost, postoje i tvari koje štete ljudskom organizmu
i izazivaju bolesti i smrt.
Najviše se proučavaju tvari koje kod čovjeka
i drugih živih bića uzrokuju rak.
Takve tvari zovu se kancerogene tvari.
Neke druge tvari su otrovne
ili izazivaju razvoj različitih bolesti.
Među njima treba istaknuti ispušne plinove
koji se oslobađaju gorenjem fosilnih goriva
te teške metale.
Nažalost, postoje i tvari koje štete ljudskom organizmu i izazivaju bolesti i smrt. Među njima najviše se proučavaju tvari koje kod čovjeka i drugih živih bića uzrokuju rak – takve tvari zovu se kancerogene tvari.
Neke druge tvari su otrovne ili potiču razvoj različitih bolesti. Među njima treba istaknuti ispušne plinove koji se oslobađaju gorenjem fosilnih goriva te teške metale.
Teški metali poput olova i žive
nastaju kao posljedica rada nekih industrija
ili izgaranjem fosilnih goriva.
Talože se u okolišu
odakle ulaze u hranidbene lance.
Najveći izvor olova u okolišu su ispušni plinovi.
Nastali su gorenjem benzina s olovom.
Zato se danas proizvodi bezolovni benzin,
ali nije dovoljno istražen.
Mnogi kemičari predviđaju štetne posljedice
uporabe takva benzina.
Teški metali poput olova i žive, koji nastaju kao posljedica rada nekih industrija ili izgaranjem fosilnih goriva, talože se u okolišu odakle ulaze u hranidbene lance.
Najveći izvor olova u okolišu bili su ispušni plinovi nastali gorenjem benzina s olovom. Zato se danas proizvodi bezolovni benzin, ali postoje prijepori i oko njegove uporabe jer mnogi kemičari predviđaju štetne posljedice uporabe takva benzina.
Klikom odaberite jedan točan odgovor.
Odaberite točan odgovor.
Koja od navedenih tvari nije teški metal i nema štetno djelovanje na organizam?
Želite li pokušati ponovo?
Mnoge tvari biljnog podrijetla
kao što su crna kava, indijski čaj
različito djeluju na čovjeka.
Sadržavaju tvari koje ubrzavaju rad srca
i povisuju krvni tlak.
Neke tvari poput nikotina iz duhana, alkohol i droge
izravno djeluju na živčani sustav.
Mogu izazvati ovisnost
kada se uzimaju dugo i u velikoj količini.
Ovisnost je bolest koja se treba liječiti.
Liječenje ovisnosti je teško i dugotrajno,
a često i neuspješno.
Mnoge tvari biljnog podrijetla imaju različite učinke na ljudski organizam. Crna kava i indijski čaj sadržavaju tvari koje ubrzavaju rad srca i povisuju krvni tlak. Neke tvari poput nikotina iz duhana, alkohol i droge izravno djeluju na živčani sustav.
Nekontrolirano i prekomjerno uživanje alkohola, nikotina, droga, nekih lijekova i drugih tvari izaziva ovisnost.
Ovisnost je bolest koja se razvija dugotrajnom konzumacijom sredstava koja uzrokuju ovisnost (nikotin, alkohol, droge, neki lijekovi i sl.). To je stanje koje treba liječiti. Liječenje ovisnosti je teško i dugotrajno, a često i neuspješno.
Gorenjem cigareta nastaju dim, katran i pepeo.
Dim sadrži smjesu plinova.
Opasan je ugljični monoksid
i neki sastojci koji izazivaju rak.
Ljudi u okolici pušača udišu dim
i postaju pasivni pušači.
Žutosmeđa tvar koja se taloži u plućima pušača je katran.
Katran sadrži brojne kancerogene tvari
i može izazvati tešku bolest – rak pluća.
U Hrvatskoj je zakonom zabranjena prodaja
duhanskih proizvoda
i točenje alkoholnih pića
osobama mlađima od 18 godina.
Gorenjem cigareta nastaju dim, katran i pepeo. Dim cigarete je smjesa plinova u kojem su uz opasni ugljikov monoksid, dokazani i neki kancerogeni sastojci. Oni štetno djeluju na pušača, ali i na nepušače koji s njima žive jer i oni udišu te štetne tvari te tako postaju pasivni pušači. Žutosmeđa tvar koja se taloži u plućima aktivnog pušača je katran. Katran sadrži brojne kancerogene tvari i može izazvati tešku bolest – rak pluća.
U Hrvatskoj je zakonom zabranjena prodaja duhanskih proizvoda i točenje alkoholnih pića osobama mlađima od 18 godina.
Na kraju…
Možemo zaključiti da tvari mogu biti štetne i korisne,
ljekovite, otrovne i hranjive.
Njihovom primjenom možemo unaprijediti
ili ugroziti život.
Na kraju…
Iz svega navedenog možemo zaključiti da tvari mogu biti štetne i korisne, ljekovite, otrovne i hranjive. Njihovom primjenom možemo unaprijediti ili ugroziti život.